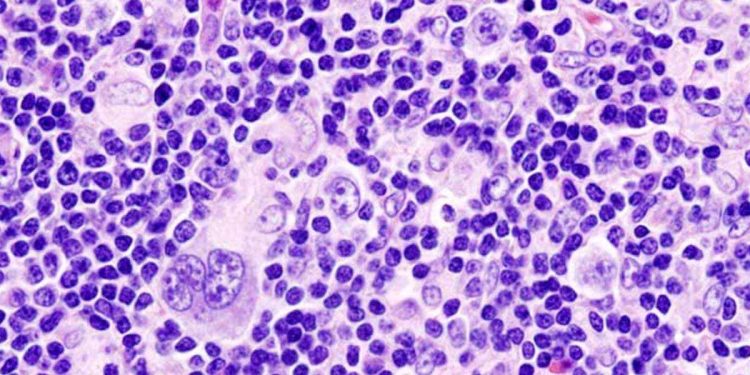
Linfoma di Hodgkin, Wikipedia

Oggi si torna a parlare del linfoma di Hodgkin, un tumore del sistema linfatico che sette mesi fa ha colpito anche Teresa Cherubini, figlia di Jovanotti, ma che con grande forza è riuscita a combattere e a sconfiggere. Il linfoma di Hodgkin è un tumore relativamente raro nonché tra i più frequenti tra i pazienti più giovani, compresi nella fascia 15-35 anni. Questo tipo di tumore del sistema linfatico si origina dai linfociti V, ovvero un tipo di globuli bianchi che si trovano in linfonodi, milza, midollo osseo, sangue ed altri organi ed ha il compito importantissimo di difendere l’organismo umano da agenti esterni e malattie. Questo tumore può intaccare diversi organi sebbene prenda spesso origine dai linfonodi. Secondo i dati diffusi da Airc, sono circa 4 persone ogni 100mila abitanti ad essere colpite dal linfoma di Hodgkin pari allo 0,5% di tutti i casi di tumore diagnosticati. Tuttavia la sua incidenza nella fascia 15-35 anni è in aumento in Europa, con una incidenza del 22% tra il 2003 ed il 2014, sebbene la mortalità sia in diminuzione.
I soggetti maggiormente a rischio sono dunque i più giovani tra 20 e 30 anni, ma anche sopra i 60 anni; gli uomini hanno un rischio leggermente maggiore delle donne. Molto dipende sempre dalla storia familiare anche se non si tratta di una malattia ereditaria. Questo tumore è più diffuso nel Nord Europa, Usa e Canada e risulta essere più comune fra le persone a elevato tenore di vita.
LINFOMA DI HODGKIN, COS’È E COME SI CURA
Nel 95% dei casi il linfoma di Hodgkin si manifesta nella sua forma classica mentre il 5% è a predominanza linfocitica. Ma quali sono i sintomi che possono rappresentare un campanello di allarme? Il primo sintomo è l’ingrossamento dei linfonodi in particolare quelli della regione cervicale. Tra gli altri possiamo anche citare febbre persistente, sudorazione notturna, perdita di peso e prurito così come stanchezza e mancanza di appetito. Se la malattia riguarda i linfonodi del torace è da considerarsi anche la tosse, il dolore al petto e le difficoltà respiratorie. Nel caso della figlia di Jovanotti tra i sintomi più spiccati vi era il prurito alle gambe che si è poi diffuso nel resto del corpo impedendole di dormire e creandole delle piaghe ovunque. Una volta diagnosticato questo tumore, la possibilità di guarire è oggi molto elevata, in quanto riguarda una percentuale che oscilla tra l’80-85%. Non è prevista la chirurgia se non per eseguire la biopsia mentre la cura consiste nella polichemioterapia e la radioterapia da sole o in combinazione.